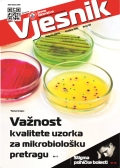

Vjesnik
Vjesnik on line (ISSN 1846-2286) Impressum
- Toplinski valovi i hospitalizacije u Općoj bolnici Dubrovnik 2013. - 2023. godine
- Specifičnosti ovisnosti o alkoholu kod žena
- Ispitivanje kakvoće mora za kupanje u Dubrovačko-neretvanskoj županiji u sezoni kupanja 2025. godine
- Akutne respiratorne infekcije
- Herpes zoster - kako i koga danas možemo cijepiti?
- Miris i okus vode u vodoopskrbnom sustavu s osvrtom na incident na izvorištu Palata
- Prehrambena bojila
- Neisseria meningitidis - najčešćI uzročnik meningitisa
- Registri za alkoholizam, patološko kockanje i ovisnost o videoigrama
- Pojavnost bolesti COVID-19 u populaciji školske djece na području Dubrovačko-neretvanske županije
- Elektroničke cigarete - predmet prijepora u javnosti
- Znanje, stav i praksa o upotrebi antibiotika – preliminarno istraživanje u odrasloj populaciji u Dubrovniku
- Utjecaj COVID-19 pandemije na izvanbolničku potrošnju antibiotika u RH

- Enterotoksogenost izolata bakterije Staphylococcus aureus iz domaćeg svježeg sira
- Porodična hiperkolesterolemija
- Cyberhondrija
- Mikroplastika
- Molekularna dijagnostika i mogućnosti u Službi za mikrobiologiju

- Ciste pinealne žlijezde u djece
- SUHA SMOKVA: Rajsko voće ili izvor pesticida
- RIJEČ KAO LIJEK: Terapijski učinci komunikacije između zdravstvenih djelatnika i pacijenata
- Što nam kazuje Popis stanovništva 2021.
- Provedba projekta EUROBATH

- TORCH infekcije u trudnoći
- Šarlah
- Stjenice
- 20 GODINA ZAVODSKOG ČASOPISA

- Molekularna biologija Humanog papiloma virusa
- Černobilska nuklearna nesreća i njezin utjecaj na zdravlje
- Utjecaj oborina na površinske i prijelazne vode rijeke Neretve
- ...
- Mikrobiološka kakvoća leda iz ledomata

- Utjecaj indeksa tjelesne mase na trajanje hospitalizacije..
- Važnost probiotika..
- Polifenoli – prirodna prevencija i terapija Covid-19 infekcije
- Trans masne kiseline
- ...
- Formiranje identiteta u digitalnom dobu

- Navike korištenja digitalnih uređaja kod djece iz Dječjih vrtića Dubrovnik
- Mladi i digitalni mediji u vrijeme pandemije bolesti COVID-19
- YouTuberi - idoli novih generacija: analiza i vrednovanje sadržaja
- Efekti prekomjernog korištenja digitalnih uređaja na ponašanje djece u ranoj dobi
- ...

- Kako priopćiti lošu vijest pacijentu
- Zašto roditelji odbijaju cijepiti svoju djecu?
- Mutnoća na krškim izvorima i njena pouzdanost u procjeni onečišćenja
- Utjecaj društvenih mreža na razvoj prehrambenih trendova
- Mentalno zdravlje u 2020. godini
- ...
- Spolno prenosive bolesti u Hrvatskoj i Dubrovačko-neretvanskoj županiji posljednjih deset godina
- Uloga školskog liječnika u promociji spolnog zdravlja mladih

- Bakteriološka dijagnostika spolno prenosivih bolesti
- Utjecaj kliničke citologije na spolno zdravlje
- Infekcija HPV virusom - što trebamo znati?
- Rak vrata maternice kao spolno prenosiva bolest
- Sifilis – veliki imitator
- Hepatitis - spolno prenosiva bolest
- Karakteristike korisnika HIV savjetovališta Dubrovnik s reaktivnim nalazom
- Erektilna disfunkcija – povijesni osvrt
- Neplodnost
- Reprodukcijske odrednice stanovništva Dubrovačko-neretvanske županije
- ...
- COVID-19: KOLIKO GA POZNAJEMO?

- ISKUSTVA STOŽERA CIVILNE ZAŠTITE DUBROVAČKO-NERETVANSKE ŽUPANIJE U EPIDEMIJI BOLESTI COVID-19
- PRIKAZ EPIDEMIJE COVID-19 U DUBROVAČKO-NERETVANSKOJ ŽUPANIJI U RAZDOBLJU OD 18. OŽUJKA DO 18. LIPNJA 2020. GODINE
- SKUSTVA ZAVODA ZA JAVNO ZDRAVSTVO DUBROVAČKO-NERETVANSKE ŽUPANIJE U EPIDEMIJI BOLESTI COVID-19
- DIJAGNOSTIKA BOLESTI COVID-19 U ODJELU ZA MIKROBIOLOGIJU DUBROVNIK
- MENTALNO ZDRAVLJE U DOBA KORONE
- O PODUZETIM AKTIVNOSTIMA U BORBI PROTIV BOLESTI COVID-19 U OPĆOJ BOLNICI DUBROVNIK
- RAD SLUŽBI DOMA ZDRAVLJA DUBROVNIK U VRIJEME PANDEMIJE BOLESTI COVID-19
- ...

- ANTIMIKROBNA REZISTENCIJA KAMPANJA „ANTIBIOTICI – DANAS LIJEČE, SUTRA MOŽDA NEĆE“
- ANTIMIKROBNA REZISTENCIJA u Dubrovačko-neretvanskoj županiji
- POTROŠNJA ANTIBIOTIKA U EUROPI I HRVATSKOJ
- EMPIRIJSKO LIJEČENJE RESPIRATORNIH I URINARNIH INFEKCIJA U VRIJEME RASTUĆE REZISTENCIJE BAKTERIJA NA ANTIBIOTIKE
- ANTIMIKROBNA REZISTENCIJA KOD ŽIVOTINJA I U HRANI
- ...

- EPIDEMIJA OSPICA
- SPOLNE RAZLIKE U INCIDENCIJI I SMRTNOSTI OD RAKA PLUĆA
- NESUICIDALNO SAMOOZLIJEĐIVANJE ADOLESCENATA
- OPSESIVNOKOMPULZIVNI POREMEĆAJ
- RAD CENTRA ZA DOBROVOLJNO SAVJETOVANJE I TESTIRANJE NA HIV
- POPUSTLJIVI ODGOJ
- LASIK - metoda laserske korekcije refraktivne anomalije
- ...

- ČOVJEKOV MIKROBIOM
- PARTNERSKI ODNOS OČIMA PSIHOTERAPEUTA – zajedništvo različitih pristupa
- Procjena kvalitete "READY TO EAT" SALATA
- LIJEČENJE OVISNIKA O PSIHOAKTIVNIM TVARIMA U ODJELU ZA MENTALNO ZDRAVLJE
- OSVRT NA IZLOŽBU: "BIŽI, BIŽI KUGA MORI"
- SIMPOZIJ "SKRB O OSOBAMA S POREMEĆAJEM IZ SPEKTRA AUTIZMA - potrebe i mogućnosti"
- ...
- Depresija - unipolarna ili bipolarna pitanje je sad
- MALA DJEČJA GLISTA (ENTEROBIUS VERMICULARIS)
- DIJABETES – da se ne zaboravi
- ANOREKSIJA: POREMEĆAJ HRANJENJA
- POREMEĆAJ IZ SPEKTRA AUTIZMA
- ISPITIVANJE OTPADNIH VODA U DUBROVNIKU
- ...
- Nacionalna kampanja "Prestanimo uzgajati komarce"
- Ispitivanje kakvoće mora na plažama Hotela Argentina, Hotela Excelsior i plaži Banje u razdoblju od 1998. do 2016. godine
- Depresija – biramo li je i zašto?
- Pregled rada Ambulante za cijepljenje u Odjelu za epidemiologiju u Dubrovniku..
- Rezultati primjene CRAFFT screening upitnika na rizično pijenje alkohola među maturantima DNŽ
- Laboratorijska dijagnostika malarije
- ...
- Sigurnost hrane u RH
- Razlika između psihoterapije i psihološkog savjetovanja
- Smjernice za postupanje kod izloženosti virusima koji se prenose krvlju
- Psihosomatske smetnje - slušajte svoje tijelo
- Kifoza i skolioza osnovnoškolske dobi u DNŽ 2004. – 2014.
- Javnozdravstvene aktivnosti
- Edukacija o invazivnim komarcima i (re)emergentnim vektorskim bolestima
- ...
- 20 godina rada Zavoda
- Dani preventive 2016. u Dubrovačko-neretvanskoj županiji
- Zaštitimo djecu dubrovačkog područja od zaraznih bolesti
- Preventiva u zajednici u općini Lumbarda
- Koliformne bakterije kao indikatorski mikroorganizami u vodi za ljudsku potrošnju
- Zika virus – Zika virusna infekcija
- Marfanov sindrom
- Public Health Hub in Dubrovnik Spring Workshop 2016
- Javnozdravstvene aktivnosti Službe za promicanje zdravlja
- ...
- Obolijevaju li stanovnici doline Neretve češće od raka?
- Preventiva u zajednici na otoku Lastovo
- Skriveni šećer
- Stres u očima terapeuta
- Psihološke promjene u trudnoći
- Morski otpad
- Sindrom suhog oka
- Izvješće o prijetnjama zaraznih bolesti
- Grlobolja uzrokovana bakterijom Arcanobacterium Haemolyticum
- ...
- Važnost procjene potreba za palijativnom skrbi u zajednici
- Boravak u prirodi i opasnosti po zdravlje
- Peludna prognoza
- Sigurno rukovanje hranom
- Učinci siromaštva na mentalno zdravlje
- Razvoj i implementacija učinkovitih i održivih javnozdravstvenih programa za zemlje jugoistočne Europe
- Odjel transfuzijske medicine u OB Dubrovnik
- Vodeći zdravstveni i socijalni problemi srednjoškolske mladeži...
- ...
- Ebola
- Obitelj i ovisnost o alkoholu
- Kako smanjiti unos soli?
- Praćenje prijava zaraznih bolesti u Dubrovačko-neretvanskoj županiji 2004.-2013.
- Gunja - Ispomoć u poplavljenim područjima Slavonije
- Uloga medicinske sestre u zdravstvenom odgoju u školskoj medicini
- Metoda kromatografije u dokazivanju Helicobacter pylori iz uzorka stolice
- Histaminsko trovanje plavom ribom
- Važnost glasnog čitanja djeci od najranije dobi
- Javnozdravstvene aktivnosti Službe za promicanje zdravlja
- Skolioza
- Jednoroditeljske obitelji
- Kontrola mikrobiološke ispravnosti domaćih sireva
- Opasnosti bazena po zdravlje
- Virtualno nasilje među djecom
- EPH gestoza
- Kardiovaskularno zdravlje djelatnika u dječjim vrtićima u DNŽ
- Javnozdravstvene aktivnosti Službe za promicanje zdravlja
- Cijepljenje
- Mikrobiologija kronične rane
- Probir depresije kod osoba s infarktom miokarda
- Hospitalizacije stranih turista u OB Dubrovnik u 2013.
- Fotoprotekcija - smjernice za pravilnu zaštitu
- Poteškoće u dijagnostici poremećaja mentalnog zdravlja...
- Savjetodavni rad liječnika psihoterapeuta u školskoj medicini
- Rak prostate
- Savjetovalište za hipertenziju u ordinaciji obiteljskog liječnika
- Provođenje HACCP sustava u praksi
- Važnost kvalitete uzorka za mikrobiološku pretragu
- Visceralna leishmanijaza
- Antirabična obrada u ZZJZ DNŽ u 2012. godini
- Stigma psihičke bolesti – Jednom ovisnik, uvijek ovisnik!
- Kronična bol, principi liječenja
- Dječja oftalmologija jučer, danas, sutra
- Javnozdravstvene aktivnosti Službe za promicanje zdravlja
- Zavod – pouzdani izvor informacija o zdravlju
- Leptospiroza
- Stanovništvo i vitalni događaji u 2011. godini
- Program „Bistrog uma bez alkohola“
- Novi pravilnik o bazenima za kupanje
- Oralni cefalosporini u liječenju bakterijskih infekcija
- Liječnički kadar: danas, sutra?!
- ... i ostale teme
- Otvoreno savjetovalište za prehranu
- Zdravstveni odgoj školske djece i studenata
- Tjedan mozga 11.- 17. ožujka
- Neke spoznaje iz područja ovisnosti
- Psihosomatski aspekt inkontinencije
- Rezistencija bakterijskih izolata u DNŽ 2007. - 2012.
- Svjetski dan zdravlja - znate li koliki je vaš tlak?
- Meningokna bolest
- Utvrđivanje Chlamdya trachomatis direktnom imunoflorescencijom
- IV. kongres školske i sveučilišne medicine
- Nacionalni program ranog otkrivanja raka maternice
- Porodi i rodilje u DNŽ od 2002. do 2011. godine
- Prijave zaraznih bolesti
- Javnozdravstvene aktivnosti Službe za promicanje zdravlja
- Vrućine - protokol o postupanju
- Melanom
- Kampilobakterioza
- Utjecaj suše na zdravstvenu ispravnost vode za piće
- Diagnostika uroinfekta kombiniranim tehnikama
- Svjetski dan zdravlja - Aktivno, zdravo starenje
- Pozdravna riječ novog ravnatelja Zavoda
- Mamografski probir zdravstvenih djelatnica
- Sheme biološke kontrole sterilizacije
- Sastanak o kakvoći mora za kupanje u DNŽ
- Voda i osiguranje hrane
- Gimnastikom do dobrog raspoloženja
- Kako školski liječnik može pomoći u boljem usklađivanju sa svojim djetetom
- Liječenje ovisnika u Pločama
- Psihologija ovisnosti
- Prenatalni probir trudnica na S. Agalactiae
- Svjetski dan AIDS-a
- Željezo u krškim vodama grada Dubrovnika
- Kronične nezarazne bolesti izazovi 21. stoljeća
- Javnozdravstvene aktivnosti odjela za socijalnu medicinu
- Hidrična epidemija gastroenteritisa - važnost pravovremene prijave oboljelih od zarazne bolesti
- Mikrobiološka dijagnostika enterohemoragične E. coli u dubrovačkom laboratoriju
- Prekidi trudnoće u DNŽ
- Prijave oboljelih od kolorektalnog raka u DNŽ, 2008.-2010.
- Zadržavanje u supstitucijskom programu - znak uspješnog liječenja ovisnosti
- Mikrobiološka kakvoća hrane u ponudi ugostiteljskih objekata u Županiji
- Znate li kakva je mikrobiološka čistoća ugostiteljskih objekata u DNŽ?
- Ispitivanje kakvoće mora na morskim plažama u DNŽ u 2010.
- Europski tjedan kretanja, 16.-22. rujna
- Prijavljene zarazne bolesti u DNŽ u 2010.
- Otpornost bakterija na antibiotike - globalni problem
- Povijest obilježavanja Međunarodnog dana voda
- Brucela u laboratoriju
- Minor malformacije - brazda četiri prsta
- Denga groznica
- Održan stručni skup "Rezistencija bakterija na antibiotike"
- Akreditacija laboratorija službe za zdravstvenu ekologiju ZZJZ DNŽ
- Dijagnostika Epstein-barr virusa od 2011. i kod nas
- Smjernice supstitucijske terapije
- Smrtnost stanovništva DNŽ od 2000.-2009. godine
- Mikrobiološka dijagnostika u 2009. godini
- HIV savjetovalište
- Mjesec borbe protiv ovisnosti
- Javnozdravstvene aktivnosti službe za promicanje zdravlja
- Hidrična epidemija s izvorišta Butina
- Izolirana Listeria Monocytogenes u lososu
- Iznenadno onečišćenje u uvali Lapad
- Clostridium Difficile - preporuke za liječnike
- Održana tribina u Pločama
- Crijevne zarazne bolesti (2005.-2009.)
- Aktivnosti odjela za socijalnu medicinu
- Prijavljene zarazne bolesti u DNŽ u 2009. godini
- Poplave u dolini Neretve
- Svjetski dan zdravlja
- Voda u ambalaži - istine i zablude
- Dijagnostika Helicobacter Pylori u stolici
- Ehlers-Danlos sindrom
- Akreditacija laboratorija zdravstvene ekologije
- Rad obiteljske medicine u DNŽ u 2008.g.
- Činjenice o cijepljenju protiv pandemijske gripe
- Gripa A (H1N1) - Kretanje oboljelih u DNŽ
- Tri godine programa Mamma u DNŽ
- Program otkrivanja raka debelog crijeva u DNŽ
- Izvanbolnički Meticilin rezistentni Staphylococcus Aureus
- Grupni rad s ovisnicima u zatvoru
- Kvaliteta mora u DNŽ u 2009. g.
- HIV savjetovalište
- Pandemija nove gripe A /H1N1/
- Dijagnostika virusa nove gripe H1N1
- Tigrasti komarac u Dubrovniku
- Melanom kože
- Samopregled kože
- Novi kriteriji i more za kupanje
- Rezistencija Klebsiella P. u 2007. g.
- Prijava maligne neoplazme
- HPV - Humani papiloma virus
- Stav o cijepljenju protiv HPV
- Cijepljenje protiv HPV
- Svjetski dan zdravlja 2009.
- Održana tribina u Metkoviću
- Neurofibromatoza tip 1
- Prijava maligne naoplazme
- Rano otkrivanje raka debelog crijeva za DNŽ U 2008. godini
- Mutnoća vode za piće
- Kakvoća mora
- Nadzor nad DDD mjerama
- Statističko istraživanje
- Rezistencija P. Aeruginosa u 2007. godini
- HIV SAVJETOVALIŠTE
- Zdravstvena ispravnost vode za piće
- Dioksini u vodi-istine i zablude
- Elektrovodljivost i pH vrijednost rijeke Omble
- Mjesec osobnog zdravlja u Županiji
- Osobe liječene zbog uporabe sredstava ovisnosti u 2007. godini
- Rezistencija E. coli na antibiotike tijekom 2006. godine
- Edukacija o samopregledu dojki u Općoj bolnici Duborvnik
- Održana CDC globalna konferencija u Cavtatu
- Novi mjesečni obrasci za cjepitelje
- Dvanaest godina Zavoda za javno zdravstvo Dubrovačko-neretvanske županije - Službe i djelatnosti
- Nacionalni program ranog otkrivanja raka debelog crijeva
- Savjetovalište za nutricionizam u Dubrovniku
- Simpozij o kardiovaskularnom zdravlju u Zagrebu
- Obilježavanje mjeseca borbe protiv ovisnosti
- Primjenjeno javno zdravstvo u Nizozemskoj
- Kakvoća mora na županijskim plažama u 2007. godini
- Akreditirani laboratorij u Austriji
- Rezistencija uzročnika na antibiotike u DNŽ u 2006. godini
- Otvorenje novih Zavodskih prostora i javnozdravstvena tribina
- Sažeci tematskog broja HČJZ-a posvećenog zdravlju u Dubrovačko-neretvanskoj županiji
- Projekt "Kontrola širenja ambrozije u Dubrovačko-neretvanskoj županiji"
- Rano pijenje kod mladih u Dubrovačko-neretvanskoj županiji
- Radionica "Sanitarna kakvoća mora i organizama iz mora (školjkaša)"
- Listopad- Mjesec starijih osoba
- Influenca ptica (Ptičja gripa)
- Konzumiranje sredstava ovisnosti među srednjoškolcima u Dubrovačko-neretvanskoj županiji u razdoblju od 2001. do 2006. godine
- Kolorektalni rak - Pilot-projekt: Screening test okultnog krvarenja u stolici
- Dramski odgoj u prevenciji ovisnosti i neprilagođenog ponašanja
- Svjetski dan srca
- Zarazne bolesti u DNŽ od 1. do 6. mjeseca 2006. godine
- Zajedno do zdravlja
- Uz Svjetski dan voda
- Zdravstvena ispravnost vode za piće u Županiji u 2005. godini
- Svjetski dan borbe protiv tuberkuloze - 24. ožujka
- Racionalna primjena antibiotika
- Ambrozija u Dubrovniku
- "Zajedno jači"
- Prionske bolesti
- Sastanak radne skupine TTB projekta za starije osobe
- Liječnici školske medicine - gosti voditelji na stručnom skupu za vjeroučitelje
- 2. hrvatski gerontološki kongres
- Prijave malignih neoplazmi
- Zarazne bolesti na području Županije u 2005. godini
- Centar za dobrovoljno savjetovanje i testiranje na HIV
- Otvaranje Savjetovališta za mlade i roditelje u okviru programa prevencije HIV/AIDS u srednjim školama i fakultetima
- Aktivnosti povodom Mjeseca borbe protiv ovisnosti
- Uloga socijalnog radnika u tretmanu ovisnika
- 13. međunarodni kongres Europske unije za školsku i sveučilišnu medicinu u Dubrovniku
- Psihičko zdravlje - ljepota različitosti
- Humani papilloma virus - molekularna dijagnostika
- TTB projekt o starijim osobama
- Kakvoća mora na plažama Dubrovačko-neretvanske županije u 2005. godini
- Klorirani organski polutanti
- Epidemija zaušnjaka u Dubrovniku
- SUBUTEX - novi lijek za heroinske ovisnike
- Osnove HACCP-a
- Kretanje TBC-a oboljenja u Dubrovačko-neretvanskoj županiji
- XI Radni sastanak o kakvoći mora na Lastovu
- Preventivni pregledi osoba starijih od 45 godina
- Ostanimo i ostarimo u Dubrovačkom primorju
- Godišnje izvješće o imunizacijama za 2004. godinu
- Treća Europska konvencija realitetne terapije
- Svaka majka i dijete su važni
- Meningokokna bolest
- Voda za život
- Tuberkuloza-drevna bolest
- Mjesec borbe protiv raka
- Listopad, mjesec starijih osoba
- Vježba Stožera operativnog centra Plana intervencija kod iznenadnog onečišćenja mora u Dubrovačko-neretvanskoj županiji
- Svjetski dan borbe protiv AIDS-a 1. prosinca
- Zadržimo im osmijeh
- Bruceloza, sredozemna groznica
- Normalna flora čovjeka
- Europski tjedan kretanja 16.-22. rujna 2004. godine
- Rad odjela za prevenciju i izvanbolničko liječenje
- Veslajmo u zdravi život
- Recite DA nepušenju
- Nedostatak željeza
- Tjedan mozga, 15.-19. ožujka
- Kakvoća mora za kupanje u Dubrovačko-neretvanskoj županiji u 2003. godini
- European antimicrobal resistance survellance sistem (EARSS)
- Svjetski dan zdravlja, 7. travnja 2004.
- Prvi hrvatski kongres preventivne medicine i unapređenja zdravlja
- Prevencija poremećaja ponašanja u lokalnoj zajednici - iskustva školskog liječnika
- Regionalne razlike u konzumiranju sredstava ovisnosti među mladima u Dubrovačko-neretvanskoj županiji i mogući pridonoseći čimbenici
- Kvalitativno istraživanje u participativnoj procjeni zdravstvenih i socijalnih potreba zajednice
- Gripa, influenza
- Tuberkuloza
- Streptokokoze-/ne/potreba sustavnog traženja kliconoštva u pučanstvu
- Prikaz indikatora rada u obiteljskoj medicini i zdravstvenoj zaštiti dojenčadi i predškolske djece u Dubrovačko-neretvanskoj županiji
- Otpadne vode
- 12. Kongres Europske zajednice za školsku i sveučilišnu medicinu
- Sveti Otac Papa u Dubrovniku
- Sunce - (ne)prijatelj naše kože
- Drugi kongres Hrvatskog senološkog društva
- Korištenje sredstava ovisnosti kod srednjoškolaca u DNŽ
- Zdrava djeca u zdravom okruženju -Svjetski dan zdravlja 7. travnja
- Zdravstveni odgoj važan segment školske medicine
- Smanjio se broj pušača među prosvjetnim djelatnicima na području Dubrovačko-neretvanske županije
- Analiza izolata iz hemokultura u 2002. godini
- SARS - atipična upala pluća
- Potaknite svoje pacijente na odvikavanje od pušenja
- Voda za piće
- Bakteriološka dijagnostika tuberkuloze
- Bolesti srca i krvnih žila
- Aktivnosti Zavoda
- Vode
- Korištenje medija u zdravstvenom prosvjećivanju
- Spolno prenosive bolesti
- Obilježavanje Međunarodnog dana borbe protiv ovisnosti 26. lipnja 2002.
- Kontrola zaraznih bolesti nekad i danas
- Epidemije u 2001. godini
- Zoonoze
- Psitakoza, Psittacosis
- Antirabična zaštita ljudi u Dubrovačko-neretvanskoj županiji u 2001.
- Novosti u Programu obveznog cijepljenja u 2002. godini
- Svjetski dan zdravlja - 7. travnja
























